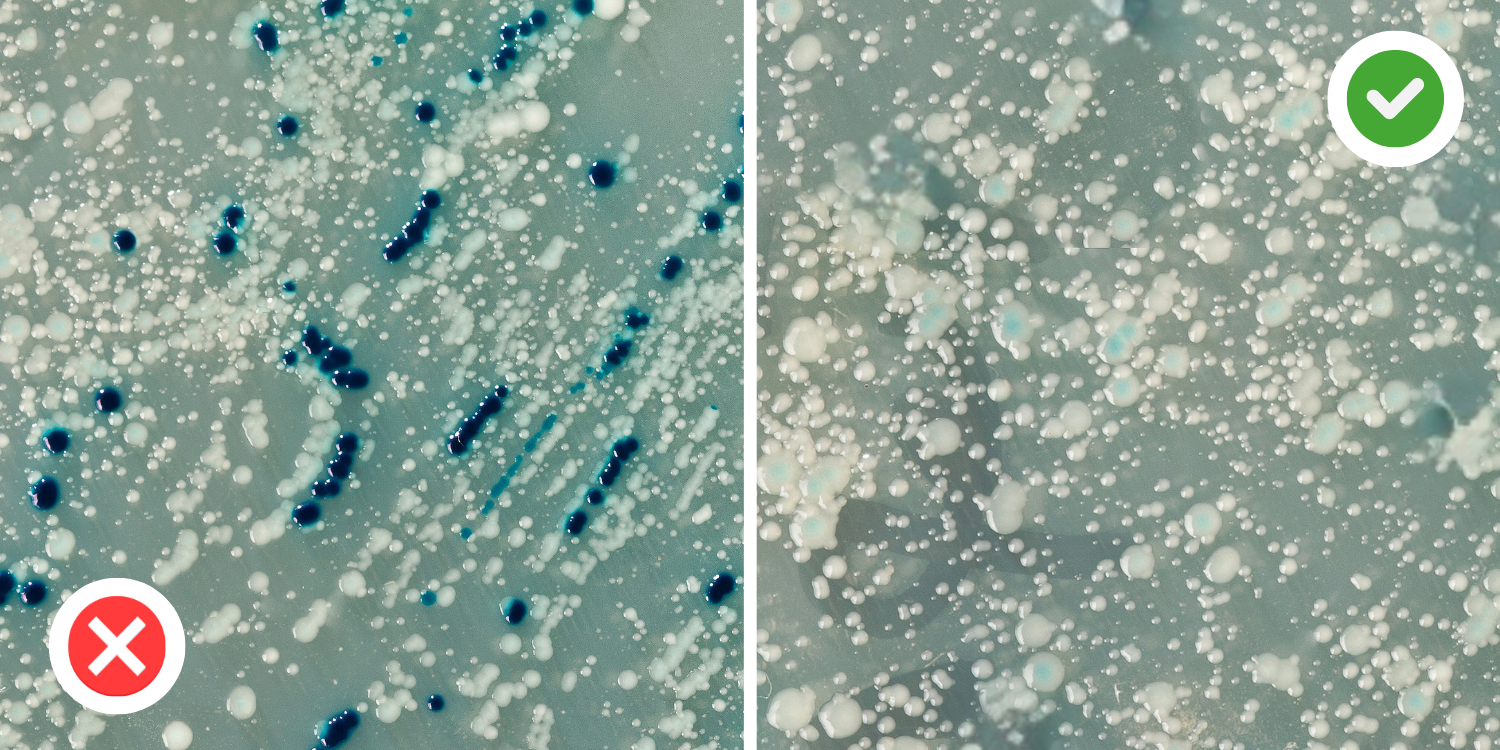

5 Healing Benefits of Sleeping on Pure Linen
You’ve probably heard of bamboo, silk, or high-thread-count cotton sheets. Some claim to be “cooling,” others “luxurious.” But when it comes to actual healing benefits, few fabrics come close to pure linen.
For thousands of years, linen has been the fabric of wellness — from ancient Egyptian bandages to sacred garments. Today, science is beginning to confirm what tradition always knew: linen doesn’t just feel good — it’s good for you.
Here are five healing ways linen supports your body and mind while you sleep:
Tuesday, November 19, 2024, at 9:17 AM EST

We’ve tried to make this as easy to understand as possible, but some terms are still research-based to ensure the information stays accurate and true to the studies.

1. Naturally Antibacterial
Unlike cotton or synthetics, linen actively resists bacteria. Flax fibers contain natural compounds that inhibit microbial growth, keeping your sheets fresher, your skin healthier, and your bed cleaner — night after night.
2. Hypoallergenic & Skin-Friendly
Sensitive skin? Allergies? Linen is hypoallergenic by nature. It produces almost no lint, repels dust mites, and has a smooth, non-irritating texture. It’s often recommended for those with eczema, asthma, or reactive skin conditions.

3. Balances Body Temperature
Healing sleep depends on thermal balance. Linen cools when it’s hot and warms when it’s cold — naturally. By preventing night sweats and chills, linen helps maintain your body’s restorative sleep rhythm.

4. Improves Sleep Quality
Multiple studies show: linen helps you fall asleep faster, sleep deeper, and wake up happier. It wicks away moisture, regulates temperature, and reduces sensory disturbances — letting your nervous system truly rest. No wonder it's called “the wellness fabric.”

5. High Vibrational Energy
Ancient wisdom meets modern curiosity: linen resonates at ~5,000 Hz, a naturally high frequency compared to other materials. Some believe this energetic resonance may support healing, vitality, and even spiritual clarity. Whether you see it as science or symbolism, linen has long been associated with elevated energy.

You can find 100% natural linen bed sets exclusively on the official Moon & Linen website
⚠️ Important: Stock is limited, so don’t miss out!
Here’s how to secure yours:
Step 1: Place your order today to reserve your 100% natural linen bed set.
Step 2: Delivered in 4–9 business days.
Step 3: Get started and feel better every day!
This exclusive offer is only available on the official Moon & Linen website.
Click the link above to check if 100% Natural Linen Bedset is in stock!






5 Healing Benefits of Sleeping on Pure Linen
You’ve probably heard of bamboo, silk, or high-thread-count cotton sheets. Some claim to be “cooling,” others “luxurious.” But when it comes to actual healing benefits, few fabrics come close to 100% pure linen.
For thousands of years, linen has been the fabric of wellness — from ancient Egyptian to sacred garments. Today, science is beginning to confirm what tradition always knew: linen doesn’t just feel good — it’s good for you.
Here are five healing ways linen supports your body and mind while you sleep:
Tuesday, August 19, 2025, at 9:17 AM EST

We’ve tried to make this as easy to understand as possible, but some terms are still research-based to ensure the information stays accurate and true to the studies.
1. Naturally Antibacterial
Unlike cotton or synthetics, linen actively resists bacteria. Flax fibers contain natural compounds that inhibit microbial growth, keeping your sheets fresher, your skin healthier, and your bed cleaner — night after night.

2. Hypoallergenic & Skin-Friendly
Sensitive skin? Allergies? Linen is hypoallergenic by nature. It produces almost no lint, repels dust mites, and has a smooth, non-irritating texture. It’s often recommended for those with eczema, asthma, or reactive skin conditions.

3. Balances Body Temperature
Healing sleep depends on thermal balance. Linen cools when it’s hot and warms when it’s cold — naturally. By preventing night sweats and chills, linen helps maintain your body’s restorative sleep rhythm.

4. Improves Sleep Quality
Multiple studies show: linen helps you fall asleep faster, sleep deeper, and wake up happier. It wicks away moisture, regulates temperature, and reduces sensory disturbances — letting your nervous system truly rest. No wonder it's called “the wellness fabric.”

5. High Vibrational Energy
Ancient wisdom meets modern curiosity: linen resonates at ~5,000 Hz, a naturally high frequency compared to other materials. Some believe this energetic resonance may support healing, vitality, and even spiritual clarity. Whether you see it as science or symbolism, linen has long been associated with elevated energy.

Final Thoughts
True healing starts with rest — and linen makes that rest deeper, cleaner, and more restorative. With its natural antibacterial properties, skin-friendly softness, and even a touch of energetic vitality, pure linen transforms your bed into a space where your body can truly repair itself.

“As a specialist, I recommend linen bedsets to my patients. Their breathability and hypoallergenic properties truly support better rest.”
★★★★★ Dr. Emily Carter, MD
You can find 100% natural linen bed sets exclusively on the official Moon & Linen website
⚠️ Important: Stock is limited!
Here’s how to secure yours:
Step 1: Order 100% natural linen bed sets today.
Step 2: Delivered in 4–9 business days.
Step 3: Get started and feel better!
This exclusive offer is only available on Moon & Linen official website.
Click the link above to check if 100% Natural Linen Bedset is in stock!







Recommended: ★★★★★
4.8 | 1,897 Reviews


Ex ad commodi consectetur





